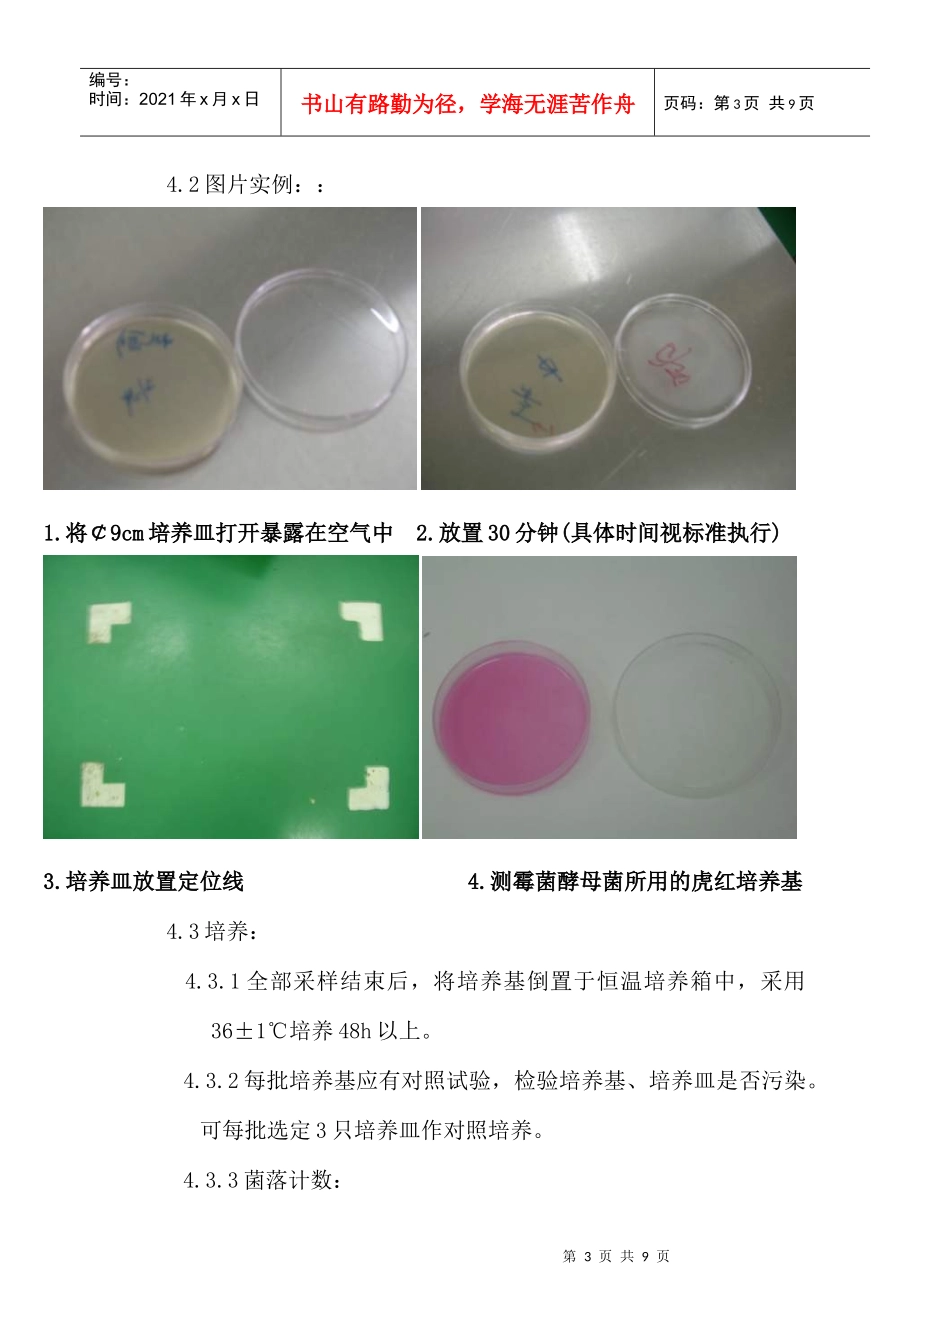
无菌微生物手册3-1 (NXPowerLite)_第3页

第1页共9页编号:时间:2021年x月x日书山有路勤为径,学海无涯苦作舟页码:第1页共9页第三部分工程卫生检测一、目的:涉及食品接触表面等的卫生状况,建立生产环境卫生状况的评价体系,为生产单位提供环境卫生控制有效性的证据,指导生产单位加强薄弱环节的卫生控制
第一章空气清洁度评价(沉降菌)1
目的:在食品生产环境中,必须保持洁净的空气,才能防止和减少来自空气的污染,对食品生产的环境进行空气的微生物学监测,是评价食品生产环境卫生、加强管理,保证食品质量的一项重要措施
仪器试药:2
(Φ90mm×15mm)2
2保温箱(36±1℃)
3高压消毒锅2
1营养琼脂培养基或其它药典认可的培养基
培养基的准备3
1将已杀菌的培养基加热溶化,冷却至45℃时,在无菌操作环境要求下将培养基注入培养皿,每皿约15ml
2待培养基凝固后,将培养基平皿倒置于36±1℃恒温培养箱中第2页共9页第1页共9页●●●●●编号:时间:2021年x月x日书山有路勤为径,学海无涯苦作舟页码:第2页共9页培养48h,若培养基平皿上确实无菌落生长,即可供采样用
2确认后准备好的培养基平皿需要在2℃---8℃的环境中存放
测试方法:4
1采样方法:4
1将已经制备好的培养皿按照下图要求进行放置,打开培养皿盖,使培养基表面暴露在空气中30min(清洁要求低于10万级水平,空气沉降菌检测只需要暴露5min),再将培养皿盖盖上后倒置保存
2工作区采样点的位置应离开地面0
8m---1
5m,离开墙面1m以上
3对于清洁区,如要求达到万级、10万级以上,则测试应该在空调系统正常运行不少于30min后开始
4沉降法最少采样点数目:饮料充填和调配区取样点均为5个;食品内包装区采用每条线1个培养皿进行取样